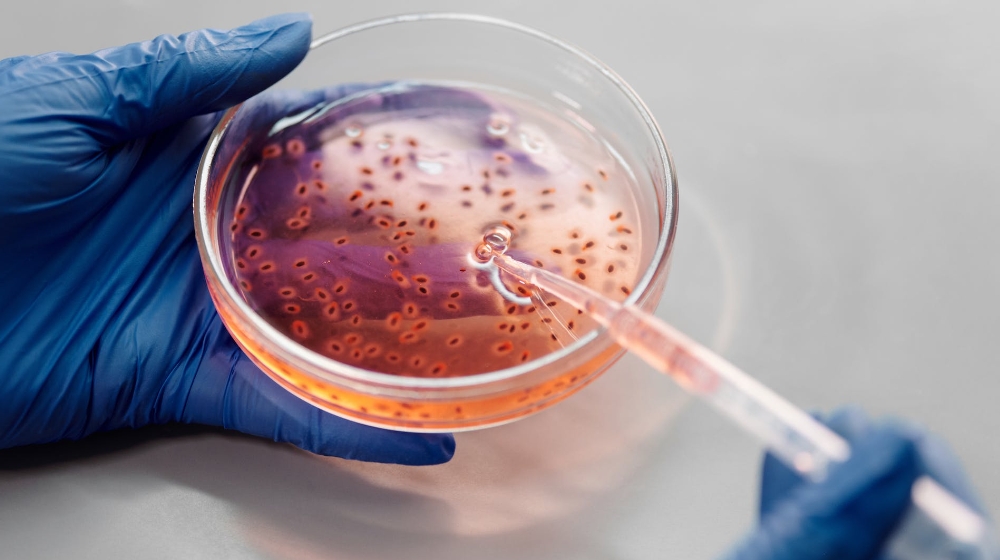

면역 체계 강화의 중요성 및 그 효과..

우리의 몸은 다양한 병원체로부터 우리를 보호하는 면역 체계를 가지고 있어요. 이 면역 체계는 우리의 건강을 유지하고, 병원체로부터 우리를 보호하는 데 중요한 역할을 해요. 따라서, 면역 체계를 강화하는 것은 건강한 삶을 유지하는 데 중요합니다. 이 글에서는 면역 체계를 강화하는 방법에 대해 알아볼게요.
면역 체계 강화 핵심 3가지!
1. 면역 체계의 이해
면역 체계는 우리의 몸을 다양한 병원체로부터 보호하는 역할을 해요. 이는 박테리아, 바이러스, 기타 병원체로부터 우리를 보호하며 우리의 건강을 유지하는 데 중요한 역할을 해요.
2. 면역 체계 강화의 중요성

면역 체계를 강화하는 것은 우리의 건강을 유지하고 다양한 질병으로부터 우리를 보호하는 데 중요해요. 또한 면역 체계를 강화하는 것은 우리의 건강한 생활을 유지하고 생활의 질을 향상시키는 데 도움이 돼요.
3. 면역 체계 강화 방법


면역 체계를 강화하는 방법은 다양해요. 이는 개인의 상황과 선호에 따라 다르며 여러 가지 방법을 조합하여 사용할 수 있어요. 영양 균형 영양소는 우리의 면역 체계를 강화하는 데 중요한 역할을 해요. 이에는 비타민 C, D, E, 아연, 셀레늄 등이 포함됩니다. 이들 영양소는 신선한 과일, 야채, 곡물, 콩, 견과류 등에서 얻을 수 있어요. 운동 규칙적인 운동은 우리의 면역 체계를 강화하는 데 도움이 돼요. 이는 심장박동을 증가시키고 우리의 몸을 건강하게 유지하는 데 도움이 돼요. 충분한 수면 수면은 우리의 몸이 복구하고 면역 체계를 강화하는 데 중요한 시간이에요. 따라서 충분한 수면을 취하는 것이 중요해요. 스트레스 관리 스트레스는 우리의 면역 체계에 부정적인 영향을 미쳐요. 따라서 스트레스 관리는 면역 체계를 강화하는 데 중요해요. 이는 명상, 요가, 호흡 연습 등 다양한 방법을 통해 이루어져요. 금연과 알코올 제한 흡연은 우리의 면역 체계에 부정적인 영향을 미치며 알코올은 우리의 면역 체계를 약화시켜요. 따라서 금연과 알코올을 제한하는 것이 중요해요.
마지막 생각..

면역 체계를 강화하는 것은 우리의 건강을 유지하고 다양한 질병으로부터 우리를 보호하는 데 중요해요. 이 글에서 소개한 면역 체계 강화 방법을 참고하여 건강한 삶을 즐길 수 있는 방법을 찾아보세요!
'라이프 건강' 카테고리의 다른 글
| 자연 요법 건강과 행복을 위한 자연의 힘! (218) | 2023.11.01 |
|---|---|
| 심리 건강 관리 행복한 삶을 위한 필수 가이드! (112) | 2023.10.31 |
| 스트레스 관리 건강한 정신을 위한 필수 가이드! (135) | 2023.10.31 |
| 효과적인 운동 루틴 건강한 몸매를 위한 필수 가이드! (135) | 2023.10.31 |
| 영양 균형 잡힌 식사 계획.. (248) | 2023.10.29 |



